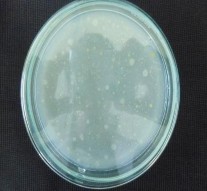

180 | 8,81 ± 0,03 | 8,25 ± 0,03 | 8,13 ±0,04 | |
270 | 8,21 ± 0,02 | 7,72 ±0,04 | 7,59 ±0,05 | |
360 | 7,54 ± 0,04 | 6,46± 0,02 | 6,86±0,03 | |
0 | 9,72 ± 0,01 | 9,52 ±0,05 | 9,26 ± 0,03 | |
30 | 9,38 ± 0,03 | 9,36 ± 0,02 | 9,11 ±0,01 | |
28 - 32 | 60 | 9,20 ± 0,03 | 9,26±0,03 | 9,01± 0,02 |
90 | 9,11 ± 0,02 | 8,95± 0,03 | 8,86 ±0,03 | |
120 | 8,92 ± 0,02 | 8,79± 0,04 | 8,70 ±0,02 | |
180 | 8,32 ±0,04 | 7,68 ±0,03 | 7,50 ±0,02 | |
270 | 7,84 ± 0.03 | 6,70 ± 0,01 | 6,89 ± 0,03 | |
360 | 6,87± 0.02 | 5,56 ±0,03 | 5,83± 0,04 |
Có thể bạn quan tâm!
-
Hình Ảnh Tra Phần Mềm Phản Ứng Sinh Hóa Của Nhóm Vi Khuẩn Aob/nob -
Kết Quả Sinh Hóa Để Xác Định 2 Chủng Vi Khuẩn C9/1, T5/3 Thuộc Chi Bacillus Sp. ( Khóa Phân Loại Bergey). -
Đường Tuyến Tính Mật Số Vi Sinh Vật Với Od600Nm -
Hàm Lượng Tan Trong Thời Gian 30 Ngày Thử Nghiệm Tôm Ở Bể -
Nghiên cứu vi khuẩn chuyển hóa nitơ trong nền đáy vùng nuôi tôm hùm panulirus sp. phục vụ nuôi trồng thủy sản - 29 -
Nghiên cứu vi khuẩn chuyển hóa nitơ trong nền đáy vùng nuôi tôm hùm panulirus sp. phục vụ nuôi trồng thủy sản - 30
Xem toàn bộ 247 trang tài liệu này.

2.7 Một số hình ảnh của lên men vi sinh vật dạng lỏng và bột.
|
Hình 2.10 Nguyên liệu từ trái qua phải : cám bắp, bã đậu nành, cám gạo và cám mì
Hình 2.11 Hình ảnh lên men tăng sinh, sản xuất lỏng và bán rắn.
PHỤ LỤC 3 (NỘI DUNG 3)
3.1. Đánh giá sự chuyển hóa N của các dòng vi khuẩn trong nước ao nuôi tôm thẻ chân trắng ở qui mô phòng thí nghiệm
Thông tin mẫu nước tôm thẻ chân trắng
Địa chỉ thu mẫu: khu nuôi tôm thẻ ở ấp Bình Phước, xã Bình Khánh, huyện Cần Giờ, TP.
HCM.
Thông tin mẫu lúc lấy nước:
+ Tôm đạt 100 con/kg (khoảng 10g/con).
+ Lúc thả nuôi mật độ là 100 ngàn con.
+ Tôm ở giai đoạn sắp thương phẩm (1,5 tháng).
+ Ao sâu 1,2 m.
+ Mẫu lấy lúc 16h30, sau cho ăn, nước ao có màu xanh lá chuối (hơi xậm).
Thông tin quá trình lấy mẫu nước tôm thẻ chân trắng:
+ Trong suốt quá trình ít thay nước (lý do: nước sông Cần Giờ khá ô nhiễm).
+ Cho tôm ăn bằng thuốc (thức ăn) bổ tôm, ngày 3 buổi.
+ Gây màu nước bằng cách đánh vôi (dùng Donomite).
+ Khoảng 9h sáng bật quạt gió 1,5 tiếng. Buổi tối khoảng 18 – 22h tăng cường quạt gió liên tục, ngừng cho ăn.
+ Kinh nghiệm: nước ao tôm hơi mặn sẽ giúp tôm mau lớn.

Hình 3.1 Thử nghiệm nước ao nuôi tôm thẻ chân trắng trong PTN
Bảng 3.1 Chỉ tiêu pH
pH ban đầu là 7,8 ± 0,2
Ngày 1 | Ngày 2 | Ngày 3 | Ngày 4 | Ngày 5 | |
NT1 | 7,6 ± 0,21 | 7,6 ± 0,24 | 7,5± 0,19 | 7,5± 0,26 | 7,4± 0,2 |
NT2 | 7,7± 0,3 | 7,5 ± 0,21 | 7,4± 0,15 | 7,4 ± 0,23 | 7,4 ± 0,2 |
NT3 | 7,7± 0,15 | 7,5 ± 0,17 | 7,4± 0,23 | 7,3± 0,21 | 7,3± 0,11 |
NT4 | 7,6± 0,19 | 7,5 ± 0,23 | 7,3 ± 0,27 | 7,5 ± 0,18 | 7,3 ± 0,28 |
NT5 | 7,6 ± 0,15 | 7,6± 0,22 | 7,5 ± 0,13 | 7,4± 0,17 | 7,4± 0,27 |
NTĐC | 7,7± 0,16 | 7,6 ± 0,26 | 7,6± 0,12 | 7,5± 0,24 | 7,5± 0,21 |
Bảng 3.2 Hàm lượng ammonia ( Ban đầu là 0,204 mg/L)
Ngày 1 | Ngày 2 | Ngày 3 | Ngày 4 | Ngày 5 | |
NT1 | 0,22ab ± 0,02 | 0,21a ± 0,020 | 0,18a± 0,021 | 0,07ab± 0,019 | 0,06ab± 0,025 |
NT2 | 0,20ab ± 0,023 | 0,19ab± 0,026 | 0,16ab± 0,031 | 0,07ab± 0,027 | 0,05ab± 0,026 |
NT3 | 0,20ab ± 0,021 | 0,18ab± 0,040 | 0,15ab± 0,025 | 0,05ab± 0,035 | 0,04ab± 0,021 |
NT4 | 0,18ab ± 0,05 | 0,16ab± 0,023 | 0,13ab± 0,021 | 0,05ab± 0,015 | 0,03b± 0,020 |
NT5 | 0,17b ± 0,06 | 0,12b± 0,015 | 0,09b± 0,015 | 0,03b± 0,020 | 0,03b± 0,021 |
NTĐC | 0,24a ± 0,01 | 0,21a± 0,020 | 0,15ab± 0,019 | 0,12a± 0,017 | 0,10a± 0,025 |
Trong cùng một cột, các giá trị có ký tự theo sau giống nhau không có sự khác biệt về mặt thống kê (P < 0,05).
Bảng 3.3 Hàm lượng nitrite ( Ban đầu là 0,108 mg/L)
Ngày 1 | Ngày 2 | Ngày 3 | Ngày 4 | Ngày 5 | Ngày 6 | |
NT1 | 0,11b ± 0,020 | 0,12bc ±0,020 | 0,13ab± 0,021 | 0,1b± 0,019 | 0,06b± 0,025 | 0,04b± 0,025 |
NT2 | 0,11b ± 0,021 | 0,12c± 0,026 | 0,13b± 0,031 | 0,1b± 0,027 | 0,07b± 0,026 | 0,04bc± 0,026 |
NT3 | 0,12ab ± 0,021 | 0,12bc± 0,040 | 0,13ab± 0,025 | 0,1b± 0,035 | 0,05c± 0,021 | 0,03cd± 0,021 |
NT4 | 0,11b ± 0,025 | 0,13a± 0,023 | 0,12b± 0,021 | 0,08c± 0,015 | 0,05c± 0,020 | 0,04de± 0,020 |
NT5 | 0,12a ± 0,026 | 0,13ab± 0,015 | 0,14a± 0,015 | 0,08c± 0,020 | 0,05c± 0,021 | 0,02e± 0,021 |
NTĐC | 0,11b ± 0,020 | 0,12c± 0,020 | 0,13b± 0,019 | 0,12a± 0,017 | 0,12a± 0,025 | 0,1a± 0,025 |
Trong cùng một cột, các giá trị có ký tự theo sau giống nhau không có sự khác biệt về mặt thống kê (P < 0,05).
Bảng 3.4 Hàm lượng nitrate ( Ban đầu là 0,204 mg/L)
Ngày 1 | Ngày 2 | Ngày 3 | Ngày 4 | Ngày 5 | Ngày 6 | ||
NT1 | 0,27b ± 0,032 | 0,31cd ±0,05 | 0,3a± 0,017 | 0,23ab± 0,01 | 0,20a± 0,03 | 0,1b± 0,02 | |
NT2 | 0,33a ± 0,06 | 0,30d± 0,02 | 0,22b± 0,07 | 0,22b± 0,02 | 0,20a± 0,05 | 0,1b± 0,04 | |
NT3 | 0,28b ± 0,02 | 0,32c± 0,01 | 0,31a± 0,02 | 0,23a± 0,03 | 0,18ab± 0,06 | 0,08c± 0,03 | |
NT4 | 0,29b ± 0,02 | 0,34b± 0,05 | 0,3a± 0,07 | 0,21b± 0,01 | 0,17b± 0,02 | 0,06cd± 0,02 | |
NT5 | 0,29b ± 0,06 | 0,36a± 0,07 | 0,3a± 0,05 | 0,21b± 0,02 | 0,16b± 0,04 | 0,05d± 0,02 | |
NTĐC | 0,21c ± 0,01 | 0,20e± 0,01 | 0,19c± 0,01 | 0,19c± 0,02 | 0,18ab± 0,03 | 0,17a± 0,03 |
Trong cùng một cột, các giá trị có ký tự theo sau giống nhau không có sự khác biệt về mặt thống kê (P < 0,05).
Bảng 3.5 Mật độ tổng vi khuẩn hiếu khí (Ban đầu là 2,7.106 CFU/ml tương ứng 6,43 log.CFU/mL)
Ngày 1 | Ngày 2 | Ngày 3 | Ngày 4 | Ngày 5 | |
NT1 | 10,65 | 9,49 | 7,30 | 7,04 | 6,23 |
NT2 | 11,61 | 9,80 | 8,38 | 7,75 | 6,20 |
NT3 | 11,83 | 10,57 | 9,18 | 8,57 | 6,91 |
NT4 | 11,76 | 10,90 | 9,62 | 8,79 | 7,08 |
NT5 | 11,79 | 7,90 | 8,67 | 9,08 | 7,08 |
NTĐC | 11,79 | 7,90 | 9,67 | 6,34 | 4,08 |
Bảng 3.6 Mật độ vi khuẩn AOB ( Ban đầu là 4,7.102 CFU/ml tương ứng 2,67 log.CFU/mL)
Ngày 1 | Ngày 2 | Ngày 3 | Ngày 4 | Ngày 5 | |
NT1 | 7,54 | 6,61 | 6,15 | 5,18 | 3,61 |
NT2 | 7,32 | 6,80 | 6,32 | 5,30 | 4,20 |
NT3 | 8,45 | 7,85 | 6,51 | 5,91 | 4,32 |
NT4 | 8,67 | 7,77 | 7,08 | 6,34 | 5,08 |
NT5 | 8,86 | 7,83 | 7,40 | 6,72 | 5,79 |
NTĐC | 2,34 | 2,26 | 2,04 | KPH | KPH |
Bảng 3.7 Mật độ vi khuẩn nitrite ( Ban đầu là 1,2.102 CFU/ml tương ứng 2.08 log.CFU/mL)
Ngày 1 | Ngày 2 | Ngày 3 | Ngày 4 | Ngày 5 | |
NT1 | 7,40 | 6,83 | 5,30 | 4,83 | 2,23 |
NT2 | 7,61 | 6,80 | 5,38 | 4,93 | 2,20 |
NT3 | 7,58 | 6,57 | 6,18 | 5,83 | 3,32 |
NT4 | 8,75 | 7,74 | 7,08 | 6,18 | 4,08 |
NT5 | 8,92 | 7,93 | 7,34 | 6,51 | 4,34 |
NTĐC | 2,00 | 1,00 | KPH | KPH | KPH |
3.2. Đánh giá sự chuyển hóa N của các dòng vi khuẩn trong nước nuôi tôm thẻ chân trắng ở qui mô bể 1m3
Bảng 3.8 Một số chỉ tiêu môi trường nước trong thí nghiệm
Các chỉ tiêu
Nghiệm
Nhiệt độ (oC) pH DO (mg/L)
thức
27,96 ± 0,94a | 29,37 ± 1,24a | 7,72 ± 0,33a | 7,76 ± 0,37a | 6,94 ± 0,56a | 6,68 ± 0,48a |
(26,0 - 29,0)* | (26,6 - 31,3)* | (7,19 - 8,10)* | (7,12 - 8,36)* | (6,17 - 8,49)* | (6,11 - 8,06) |
28,06 ± 0,96a | 29,26 ± 1,21a | 7,72 ± 0,22a | 7,65 ± 0,23a | 6,96 ± 0,56a | 6,67 ± 0,54a |
(26,0 - 29,6)* | (26,8 - 31,3)* | (7,24 - 8,01)* | (7,09 - 8,19)* | (6,01 - 8,45)* | (6,02 - 8,30) |
28,06 ± 0,95a | 29,30 ± 1,18a | 7,78 ± 0,16a | 7,62 ± 0,24a | 6,97 ± 0,52a | 6,59 ± 0,48a |
(26,1 - 29,5)* | (26,8 - 30,9)* | (7,23 - 8,04)* | (6,99 - 8,06)* | (6,29 - 8,43)* | (6,01 - 8,02) |
28,05 ± 0,90a | 29,19 ± 1,15a | 7,74 ± 0,17a | 7,61 ± 0,24a | 6,86 ± 0,54a | 6,50 ± 0,48a |
(26,2 - 29,6)* | (26,8 - 30,7)* | (7,10 - 8,04)* | (7,04 - 8,17)* | (5,45 - 8,35)* | (5,91 - 7,90) |
Buổi sáng Buổi chiều Buổi sáng Buổi chiều Buổi sáng Buổi chiều
NTĐC
NT1 NT2
NT3
Mean ± độ lệch chuẩn, * : khoảng biến thiên, Trong cùng một hàng và cùng chỉ tiêu, các giá trị trung bình có kí tự giống nhau không có sự khác biệt về mặt thống kê (P <0,05).
Bảng 3.9 Một số chỉ tiêu môi trường nước khác trong thí nghiệm
Nghiệm thức | |||||
NTĐC | NT1 | NT2 | NT3 | ||
Độ kiềm (mg/L) | 106,75 ± 31,74a 53,67 – 140,67* | 110,95 ± 21,99a 82,67 – 144,00* | 121,25 ± 18,45b 84,67 – 139,00* | 121,19 ± 15,83b 82,67 – 144,00* | |
Độ mặn (o/oo) | 20 ± 0,01a | 20 ± 0,01a | 20 ± 0,01a | 20 ± 0,01a |
Mean ± độ lệch chuẩn, * : khoảng biến thiên, Trong cùng một hàng và cùng chỉ tiêu, các giá trị trung bình có kí tự giống nhau không có sự khác biệt về mặt thống kê (P <0,05).
Bảng 3.10 Mật độ vi khuẩn hiếu khí (log10.CFU/mL)
Ngày thu mẫu | Lần | NTĐC | NT1 | NT2 | NT3 |
26-Nov | 4,70 | 4,81 | 5,78 | 5,34 | 4,70 |
29-Nov | 4,37 | 5,30 | 5,56 | 6,53 | 4,37 |
02-Dec | 4,85 | 6,40 | 6,65 | 5,98 | 4,85 |
05-Dec | 5,90 | 6,56 | 6,69 | 6,38 | 5,90 |
08-Dec | 6,03 | 6,75 | 6,50 | 6,35 | 6,03 |
11-Dec | 5,83 | 6,41 | 6,30 | 6,36 | 5,83 |
5,78 | 6,75 | 6,88 | 6,41 | 5,78 | |
17-Dec | 5,65 | 6,41 | 5,59 | 6,18 | 5,65 |
20-Dec | 5,73 | 6,44 | 6,02 | 6,04 | 5,73 |
23-Dec | 6,86 | 6,89 | 6,54 | 5,68 | 6,86 |
26-Dec | 6,94 | 7,55 | 7,28 | 7,25 | 6,94 |
29-Dec | 6,85 | 7,48 | 7,30 | 7,70 | 6,85 |
Ghi chú: Ngày thả tôm là ngày 23/11
Bảng 3.11 Mật độ vi khuẩn vibrio (log10.CFU/mL)
Ngày thu mẫu | Lần | NTĐC | NT1 | NT2 | NT3 |
26-Nov | 1 | 3,18 | 3,32 | 2,28 | 2,23 |
29-Nov | 2 | 3,40 | 3,18 | 2,48 | 2,54 |
02-Dec | 3 | 4,94 | 4,11 | 3,14 | 3,11 |
05-Dec | 4 | 5,17 | 4,33 | 3,28 | 3,19 |
08-Dec | 5 | 5,10 | 4,10 | 3,11 | 3,14 |
11-Dec | 6 | 5,27 | 4,27 | 3,26 | 3,22 |
14-Dec | 7 | 5,30 | 4,27 | 3,29 | 3,30 |
17-Dec | 8 | 6,34 | 4,29 | 3,29 | 3,25 |
20-Dec | 9 | 6,39 | 4,26 | 3,25 | 3,20 |
23-Dec | 10 | 6,70 | 4,29 | 4,24 | 4,28 |
26-Dec | 11 | 6,81 | 5,28 | 4,28 | 4,31 |
29-Dec | 12 | 6,85 | 5,30 | 4,34 | 4,26 |
Ghi chú: Ngày thả tôm là ngày 23/11
Bảng 3.12 Mật độ vi khuẩn A0B (log10.CFU/mL)
Ngày thu mẫu | Lần | NTĐC | NT1 | NT2 | NT3 |
26-Nov | 1 | KPH | KPH | KPH | KPH |
29-Nov | 2 | KPH | 3,87 | 3,94 | 3,97 |
02-Dec | 3 | 3,32 | 3,46 | 3,61 | 3,56 |
05-Dec | 4 | 3,72 | 3,79 | 3,67 | 4,78 |
08-Dec | 5 | 3,61 | 4,79 | 4,75 | 4,88 |
11-Dec | 6 | 3,94 | 4,87 | 4,86 | 5,99 |
14-Dec | 7 | 3,88 | 4,92 | 4,82 | 6,01 |
17-Dec | 8 | 4,69 | 5,75 | 5,97 | 5,90 |
20-Dec | 9 | 4,45 | 5,56 | 5,74 | 5,77 |
23-Dec | 10 | 4,62 | 5,65 | 6,81 | 6,75 |
26-Dec | 11 | 4,84 | 5,86 | 6,90 | 6,96 |
29-Dec | 12 | 4,83 | 5,95 | 6,04 | 6,18 |
Ghi chú: Ngày thả tôm là ngày 23/11
Bảng 3.13. Mật độ vi khuẩn NOB (log10.CFU/mL)
Ngày thu mẫu | Lần | NTĐC | NT1 | NT2 | NT3 |
1 | KPH | KPH | KPH | KPH | |
29-Nov | 2 | KPH | KPH | KPH | KPH |
02-Dec | 3 | KPH | KPH | 3,78 | 3,87 |
05-Dec | 4 | KPH | 2,80 | 3,26 | 3,37 |
08-Dec | 5 | 2,50 | 3,54 | 3,52 | 3,51 |
11-Dec | 6 | 2,62 | 3,78 | 4,66 | 4,85 |
14-Dec | 7 | 3,92 | 3,81 | 4,78 | 4,91 |
17-Dec | 8 | 3,86 | 4,83 | 4,81 | 4,93 |
20-Dec | 9 | 3,61 | 4,68 | 5,59 | 5,90 |
23-Dec | 10 | 3,47 | 4,53 | 5,74 | 5,77 |
26-Dec | 11 | 4,57 | 4,68 | 6,88 | 6,75 |
29-Dec | 12 | 4,75 | 5,75 | 6,51 | 6,92 |
Ghi chú: Ngày thả tôm là ngày 23/11
Bảng 3.14 Tăng trưởng và tỷ lệ sống của tôm
Tỷ lệ sống (%) | WG (g/con) | SGR %/ngày | |
NTĐC | 64,92 ± 23,41c | 0,44±0,06b | 15,22 ±0,5c |
NT1 | 89,97 ± 6,96ab | 0,52±0,06b | 14,70 ±0,64bc |
NT2 | 79,63 ± 11,20b | 0,68±0,04a | 16,61±0,48a |
NT3 | 93,87 ± 2,73a | 0,65±0,04a | 16,39±0,2ab |
3.3 Các yếu tố ảnh hưởng đến môi trường nước nuôi tôm
pH
Theo quy luật tự nhiên, pH buổi sáng thường thấp hơn buổi chiều. Sự dao động pH trong ngày cho phép nhỏ hơn 0,5 đơn vị, nếu lớn hơn 1 đơn vị/ngày phải can thiệp bằng hóa chất hoặc thay nước để giảm khoảng cách dao động Ngoài ra, pH còn tác động gián tiếp đến đời sống của thủy sinh vật thông qua việc làm gia tăng độc tính của NH3 trong trường hợp pH tăng cao và H2S tăng cao khi pH môi trường ao nuôi giảm. Theo Boyd (1990), khi pH giảm sẽ làm ngưng quá trình phân hủy vật chất hữu cơ làm cho các chất hữu cơ phân hủy không hoàn toàn. Điều này sinh ra nhiều độc tố trong môi trường ao nuôi.
Nhiệt độ
Trong ao nuôi nhiệt độ là yếu tố quan trọng ảnh hưởng đến các quá trình sinh tổng hợp các chất hữu cơ cho sinh vật. Theo Whetstone và ctv, (2002) tôm có thể sống tốt ở nhiệt độ 23 – 24 oC, tối ưu là 26 – 29 oC và nhiệt độ trong ngày không dao động quá 5 oC (Boyd và ctv, 2003).
Oxy hòa tan (DO – Dissolved Oxygen)
Oxy hòa tan trong ao nuôi tôm là một trong những yếu tố quan trọng đối với sự sinh trưởng và phát triển của tôm. Hàm lượng oxy hòa tan thường thấp vào ban đêm (từ 1 – 6 giờ sáng) và cao nhất vào lúc 10 – 16 giờ nhờ sự quang hợp của phiêu sinh thực vật. Trong ao nuôi tôm hàm lượng oxy hòa tan > 4 mg/L là tốt nhất, khi lượng oxy hòa tan < 4 mg/L tôm vẫn ăn bình thường, nhưng hiệu quả thức ăn bắt đầu giảm và tăng các nhân tố gây bệnh. Nếu lượng oxy hòa tan tiếp tục xuống thấp hơn tôm sẽ ngừng ăn, bơi trên mặt nước và tấp vào mé bờ ao (thành bể), nếu không xử lý kịp thời hiện tượng thiếu oxy sẽ dẫn đến tôm chết (khi hàm lượng oxy hòa tan < 1mg/L). Được cung cấp đủ oxy, tôm ăn khỏe hơn (Thái Bá Hổ và Ngô Trọng Lư, 2003). Tôm thẻ chân trắng thường lột xác đồng loạt vào ban đêm - thời điểm DO xuống thấp, khi lột xác mang tôm hấp thu oxy kém nên nhu cầu oxy cần nhiều hơn lúc bình thường. Nếu thiếu oxy xảy ra lúc lột xác, tôm sẽ chết đồng loạt ở đáy ao (bể) (vì quá trình lột xác xảy ra ở đáy ao/bể).
Độ kiềm
Độ kiềm tổng cộng chỉ khả năng trung hòa acid của nước. Độ kiềm tổng cộng cũng thể hiện tổng số các ion có tính bazơ trong nước như bicarbonat (HCO3-), carbonat (CO3-) và hydroxit (OH-
). Bicarbonat là dạng chính của độ kiềm. Hàm lượng carbonat và hydroxit có thể cao khi phiêu sinh thực vật hoạt động mạnh hoặc trong một số loại nước nhất định hoặc trong nước thải.
Theo Charantchakool và ctv (2003), độ kiềm lý tưởng cho tăng trưởng và phát triển của tôm nuôi là từ 80 – 120 mgCaCO3/L, độ kiềm thấp hơn 40 mgCaCO3/L ảnh hưởng không tốt đến sức khỏe tôm nuôi. Khi độ kiềm thấp, pH sẽ biến động và gây stress, giảm tăng trưởng và thậm chí gây chết tôm.
Độ mặn
Độ mặn ảnh hưởng trực tiếp đến việc điều hòa áp suất thẩm thấu của thủy sinh vật trong ao nuôi. Các thay đổi độ mặn vượt ra ngoài giới hạn thích ứng của tôm trong ao nuôi đều gây ra các phản ứng sốc của cơ thể làm giảm khả năng đề kháng bệnh của tôm. Theo Samocha (2019), tôm thẻ chân trắng có thể sống được ở độ mặn 20 – 35‰.
Ammonia tổng cộng (TAN - Total Ammonia Nitrogen)
Với loài tôm, ammonia có thể chiếm tới 40 – 90% các chất bài tiết nitrogen (Vũ Thế Trụ, 1995). Ammonia rất độc đối với tôm, khi có nồng độ trong ao/bể khoảng 1 mg/L có khả năng gây hiện tượng tôm chết, khi nồng độ lớn hơn 0,1 mg/L sẽ ảnh hưởng đến sự tăng trưởng của tôm. Do đó, cần duy trì nồng độ NH3 nhỏ hơn 0,1 mg/L để an toàn cho tôm nuôi (Boyd, 1998).
NH3 được cung cấp trong các thủy vực từ quá trình phân hủy bình thường các protein, xác bã động thực vật, sản phẩm bài tiết của động vật hay từ phân bón vô cơ và hữu cơ, trong đó nguồn NH3 chủ yếu từ sự bài tiết trực tiếp của động vât thủy sinh (Chen và ctv, 1998)
Khi pH tăng, sự chuyển đổi từ NH4+ sang NH3 cũng tăng, gây độc cho tôm. NH3 có độc tính
4
cao hơn NH + vì NH3 không mang điện tích dễ thấm qua tế bào mang cá, tôm, đồng thời có khả
năng hòa tan chất béo (Phạm Văn Ty và Vũ Nguyên Thành, 2009). Khi hàm lượng NH3 trong nước cao sẽ làm cho sinh vật khó bài tiết NH3 từ máu và các mô ra môi trường nước. Vì vậy, nồng độ ammonia trong máu tăng dẫn đến tổn hại các cơ quan bên trong đặc biệt là gan và thận. Đặc tính gây độc của ammonia dựa vào tính chất kích thích của hợp chất này. Không giống như người và động vật, cá và giáp xác không có khả năng bài tiết cũng như chuyển hóa ammonia thành dạng ít độc. Sự hiện diện của NH3 trong ao nuôi phụ thuộc vào nhiều yếu tố trong đó đáng kể nhất là độ mặn , nhiệt độ và pH. Nếu NH3 > 1,0 mg/L có thể gây chết tôm, NH3 < 1,0 mg/L và > 0,1mg/L tôm tăng trưởng kém, NH3 < 0,1 mg/L tôm phát triển tốt và khi tổng hàm lượng ammonia (TAN) > 2 mg/L sẽ gây chết tôm (Phạm Minh Nhựt, 2014).
Nitrite và Nitrate
Độc tính của nitrite tác động đến hệ thống tuần hoàn và hệ thống miễn dịch của động vật. Nitri e xâm nhập vào máu và kìm hãm việc gắn oxy vào sắt của hemoglobin nên ngăn cản khả năng vận chuyển oxy. Tuy nhiên, đối với tôm cũng như các động vật không xương sống khác, không có chứa hemoglobin. Thay vào đó oxy gắn vào nhân đồng trên mang và sau đó vận chuyển oxy vào trong cơ thể. Ảnh hưởng về mặt sinh lý và mô học của nitrite trên động vật không xương sống vẫn chưa được nghiên cứu rõ ràng nhưng cũng có khả năng nitrite tác động lên nhân đồng trong hệ thống tuần hoàn của tôm. Nồng độ NO2 gây ảnh hưởng nghiêm trọng đến sự phát triển của tôm khi hàm lượng. Để xác định ảnh hưởng của độc tính NO3 đối với tôm cần dựa vào tỷ lệ sống và tốc độ tăng trưởng của tôm. Do đó, người nuôi nên quan tâm đến việc giữ sức khỏe tôm thông qua việc đánh giá các đặc điểm khác như râu, mang và gan tụy. Đồng thời, người nuôi cần cẩn trọng khi nuôi tôm ở hàm lượng NO3 trong nước trên 220 mg/l và giảm hàm lượng NO3 khi nuôi tôm ở độ mặn thấp. Nitrate không độc trừ phi nó hiện diện trong nước với hàm lượng vượt quá 100 mg/L (Colt & Armstrong, 1979).
Vi khuẩn Vibrio
Bệnh Vibriosis là tên gọi chung cho các bệnh khác nhau ở động vật thủy sản do vi khuẩn Vibrio sp. gây ra. Một số chủng có khả năng tiết ra các men kitinasa, lipase, proteaza gây nên hiện tượng ăn mòn hoại tử (Tem Dound, 1994). Đa số các bệnh nhiễm khuẩn xảy ra là do tác nhân gây bệnh Vibrio spp (V. harveyi, V. splendid, V.alginolyticus, V. parahaemolyticus) và một số loài khác (Nguyễn Thị Ngọc Tĩnh và ctv, 2010). Hầu hết các giống Vibrio spp đều phân bố trong môi trường nước mặn. Môi trường Thiosulphate Citrate Bile Salt Agar (TCBS) là môi trường chọn lọc của Vibrio spp.
Hình 3.2 Một số hình ảnh thử nghiệm tôm
Vi khuẩn Vibrio
A. Tổng vi khuẩn hiếu khí B. vi khuẩn AOB C. vi khuẩn NOB
Hình 3.3 Mật số vi khuẩn Vibrio sp., mật số vi khuẩn AOB, NOB và tổng vi khuẩn hiếu khí







